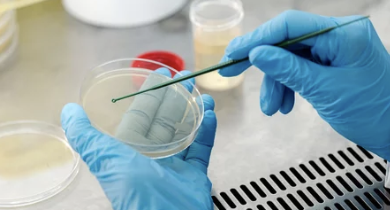

다이어트 보조제 추천 순위 BEST 7 (효과 및 성분 총정리)
다이어트 보조제는 체중 감량을 좀 더 효과적으로 도와주는 건강기능식품입니다. 다양한 제품들이 출시되어 있지만, 각각의 성분과 효과를 꼼꼼히 살펴보고 본인의 다이어트 방식과 체질에 맞는 제품을 선택하는 것이 중요합니다.
이번 글에서는 2025년 가장 인기가 높고 효과가 검증된 다이어트 보조제 순위 7가지와 각 제품의 효과, 성분, 복용법, 주의사항까지 자세히 알려드리겠습니다.
✅ 1위: 가르시니아 캄보지아 (Garcinia Cambogia)



가르시니아는 탄수화물이 지방으로 합성되는 것을 막아주는 대표적인 다이어트 성분입니다.
- 주요 성분: HCA (하이드록시시트릭산)
- 기대 효과:
- 체지방 감소 및 지방 축적 억제
- 식욕 억제로 과식 예방
- 권장 복용량: 하루 750~2,800mg (HCA 함량 기준)
- 섭취 방법: 식전 30분~1시간 전에 섭취
✅ 2위: 녹차 추출물 (카테킨)



녹차 추출물은 체내 지방 분해를 촉진하고 신진대사를 높여주는 성분으로, 대표적인 천연 다이어트 보조제입니다.
- 주요 성분: EGCG (에피갈로카테킨 갈레이트)
- 기대 효과:
- 기초대사량 증가
- 체지방 감소 촉진
- 항산화 작용 및 건강 증진 효과
- 권장 복용량: 하루 250~500mg (카테킨 함량 기준)
- 섭취 방법: 식후 30분 이내 또는 운동 전 섭취
✅ 3위: CLA (공액리놀레산)



CLA는 체지방 감소와 근육 증가를 동시에 도와주는 인기 있는 보조제입니다.
- 주요 성분: 공액리놀레산(오메가-6 지방산의 일종)
- 기대 효과:
- 복부 지방 감소 촉진
- 근육량 유지 및 증가
- 요요현상 예방에 도움
- 권장 복용량: 하루 2,000~3,000mg
- 섭취 방법: 식사 직후 복용이 권장됨
✅ 4위: 키토산 (Chitosan)



키토산은 음식물의 지방 흡수를 막아주는 효과로 다이어트 시 지방 섭취가 많은 분들께 추천하는 보조제입니다.
- 주요 성분: 갑각류 껍질에서 추출된 키틴 성분
- 기대 효과:
- 섭취한 음식의 지방 흡수 억제
- 콜레스테롤 수치 감소
- 권장 복용량: 하루 1,000~3,000mg
- 섭취 방법: 지방 함유 음식 섭취 전 30분 이내 복용
✅ 5위: 시서스 추출물 (Cissus)



최근 몇 년간 급부상한 시서스는 식욕 억제 및 지방 분해 효과로 인기를 얻고 있습니다.
- 주요 성분: 퀘르세틴, 이소람네틴 등 플라보노이드 성분
- 기대 효과:
- 식욕 억제 및 포만감 유지
- 체내 지방 분해 촉진
- 혈당 및 콜레스테롤 개선 효과
- 권장 복용량: 하루 300~600mg
- 섭취 방법: 식사 30분 전 또는 운동 전 복용
✅ 6위: 프로바이오틱스 (유산균)

장 건강을 돕는 프로바이오틱스는 장내 유익균 증가와 배변활동 촉진으로 간접적인 체중 관리에 도움을 줍니다.
- 주요 성분: 락토바실러스, 비피더스균 등 유익균
- 기대 효과:
- 장 건강 개선 및 변비 예방
- 복부 팽만감 완화 및 체중 관리 보조
- 권장 복용량: 1일 10~100억 CFU (균수 단위)
- 섭취 방법: 식사 후 꾸준히 복용
✅ 7위: L-카르니틴 (L-Carnitine)



L-카르니틴은 체내 지방을 에너지로 전환하여 운동효과를 높이는 성분으로, 운동 병행 시 가장 효과적입니다.
- 주요 성분: L-카르니틴
- 기대 효과:
- 체지방 분해 촉진 및 에너지 전환
- 운동 수행능력 향상
- 피로감 완화 및 활력 증진
- 권장 복용량: 하루 500~2,000mg
- 섭취 방법: 운동 30~60분 전 섭취 시 효과적
✅ 다이어트 보조제 복용 시 주의사항



다이어트 보조제는 올바른 섭취가 중요합니다. 복용 시 다음과 같은 주의사항을 꼭 기억하세요.
- 과다 복용 주의: 권장 복용량 초과 시 소화불량, 복통 등 부작용 발생 가능
- 충분한 수분 섭취 필수: 보조제 섭취 시 하루 1.5~2리터 이상의 물 섭취
- 기본 생활습관 유지: 보조제만으로 체중 감량은 어려우며, 반드시 운동 및 식단 관리 병행 필수
- 개인별 체질 고려: 복용 후 이상 증상 시 즉시 중단하고 의사 상담 필수
✅ 다이어트 보조제 효과적으로 활용하는 팁
- 운동 시 지방 연소 효과를 높이고 싶다면 L-카르니틴 추천
- 탄수화물 섭취가 많은 분이라면 가르시니아가 효과적
- 잦은 공복감과 과식 습관이 고민이라면 시서스가 도움
- 변비 및 복부 팽만감이 고민이라면 프로바이오틱스 추가 섭취 추천
✅ 마무리하며: 다이어트 보조제 활용 핵심 정리
다이어트 보조제는 체중 감량 목표를 더욱 효과적으로 이루는 데 도움이 되는 보조수단입니다. 그러나 근본적인 체중 관리 성공을 위해서는 운동과 식이요법 등 기본 생활 습관 개선이 우선적으로 필요합니다. 본인의 식습관과 운동 스타일에 맞는 보조제를 선택하여 더 건강하고 효율적인 다이어트를 진행해 보시기 바랍니다.
'건강한 몸을 위한 정보들' 카테고리의 다른 글
| B형 독감 증상 완벽 정리 (초기 증상부터 합병증까지) (0) | 2025.03.28 |
|---|---|
| 식욕부진 원인 6가지 (정확한 원인 분석과 해결법까지) (0) | 2025.03.28 |
| 당화혈색소 낮추는 방법 (효과적인 관리법 총정리) (0) | 2025.03.27 |
| 하지정맥류 수술비용 및 치료 방법 총정리 (0) | 2025.03.19 |
| 항문이 가려운 이유 및 해결 방법 총정리 (0) | 2025.03.19 |